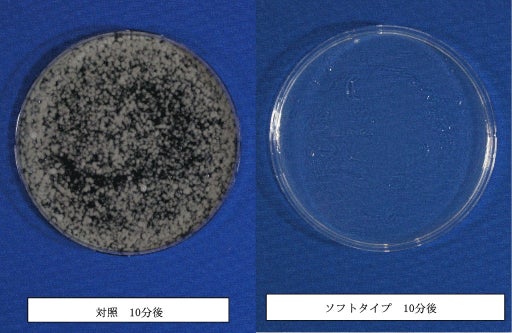

この度、株式会社E-Surf(東京都新宿区、代表取締役・田中颯人)は、カビ取りスプレー「カビ取りラボ ソフトタイプ」を2025年5月下旬から発売いたします。

図1 製品イメージ
<簡単に今まで難しかった素材に対応>
生活の中でどうしても発生してしまうカビ、毎日の清掃をしていても目の届きにくい「窓枠」や「カーテン」「家具」「家具裏の壁紙」「畳」などは、気がついた時にはカビが広がり悲惨な状態になっていることがあります。そういった水洗いが難しい場所やモノに対するカビの除去は、「強力過ぎる薬剤は怖くて使えない」と強力なカビ取り洗浄剤の使用を躊躇する人が沢山いました。
そのような人たちの「家の中の様々な場所やモノに使用できるカビ取り洗浄剤があったら良いのに」というニーズに対応する、マイルドな成分設計にこだわったソフトタイプのカビ取り洗浄剤を製品化しました。
マイルドな成分設計ではありますが、製品に配合したナノ粒子化したホタテ貝殻パウダー(水酸化カルシウム)が、カビの奥深くまで優れた除菌作用を発揮。水洗いができない場合でも水拭きと乾燥だけで、簡単に使用いただける製品に仕上げました。
<クロカビの胞子を99.9%除菌・木材にも使えるカビ取り洗浄剤>
図2 クロカビの除菌効力試験
図3 カビ取り試験(木材)
暮らしの中で見かけることが多く、一般的ですがシックハウスの症候群の原因にもなる黒カビを、99.9%除去できる本製品は、住宅材に多い木材を痛めることなく黒カビの除去が可能。※2。
また、酸素系の漂白剤では難しいカビの色素の漂白も対応可能で、青カビや赤カビ・緑カビ・白カビと幅広いカビにも、この一本で対応できます※1。
梅雨や夏場には湿度が高く木材が多様に使用される日本の住宅環境に置いて、木材に使用できるカビ取り洗浄剤は、日頃のカビ対策の強い味方となります。
<人にも環境にもやさしい、低臭気・低刺激設計&エコ仕様>
マイルドな成分設計のため、強い刺激や臭気を感じにくく、一般家庭でも安心してご使用いただける製品です。また国内流通・輸出共に出荷の多いホタテ貝は、残渣(ざんさ)物として大量の貝殻が廃棄されていますが、環境への負担が懸念されています。本製品は、その廃棄されるホタテ貝の貝殻をパウダーにした素材を活用。環境にもやさしくSDGsの12番の目標「つくる責任、つかう責任」が掲げる「廃棄物の発生の大幅な削減」に貢献できる製品設計となっています。
(※1すべてのカビに効果があるわけではありません。※2すべての木材に影響が無いわけではありません。)
<製品詳細>

図4 製品写真
□ 品名:カビ取り用洗浄剤
□ 成分:次亜塩素酸塩、水酸化ナトリウム(0.5%)
水酸化カルシウム(ホタテ貝殻由来)
非イオン界面活性剤 (アルキルアミンオキシド、アルキルエーテル硫酸エステルナトリウム)
□ 液性:アルカリ性
□ 価格:オープン価格(参考価格 ¥1,980-税込)
□ 本体容量:450g
□ 対象箇所:木材、たんす、ベニア板、木製家具、カラーボックス、押入れ、柱、ベッドのフレーム、マットレス、レースのカーテン、布団、畳 など
□ 製品URL:https://www.amazon.co.jp/dp/B0DZBSGX6M
<会社概要>
会社名:株式会社E-Surf
代表者:代表取締役社長 田中 颯人
所在地:160-0075 東京都新宿区高田馬場2-17-3
設立:2023年10月